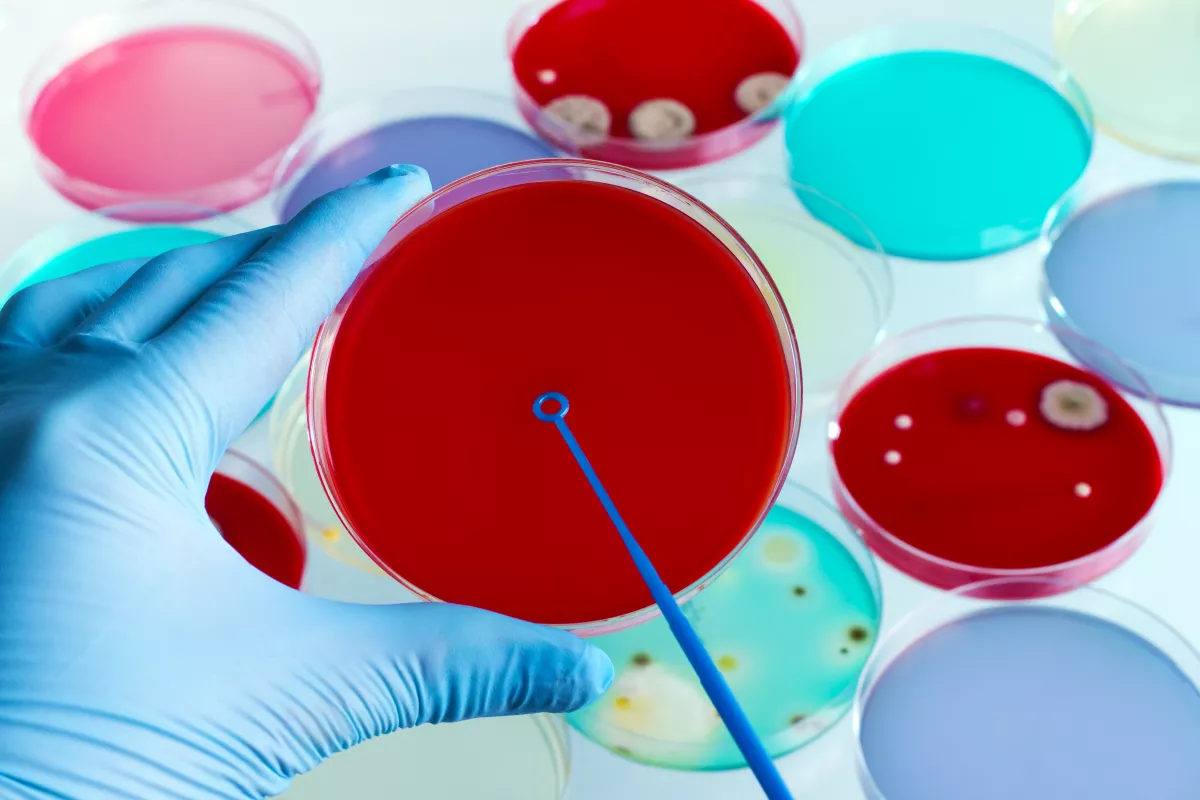
Vettél ilyen kolbászt? Nehogy megedd! Vidd vissza!

Vettél ilyen kolbászt? Nehogy megedd! Vidd vissza!
Visszahívott a forgalomból a Nemzeti Élelmiszerlánc-biztonsági Hivatal egy kolbászt. Egy baktériumot találtak benne.
A honlapján közölte a NÉBIH, hogy baktériumot találtak egy termékben, ami miatt visszahívták.

"Németország élelmiszerbiztonsági hatóságának RASFF bejelentése szerint szulfitredukáló Clostridium baktériumot mutattak ki a Zimmermann márkájú „ Bio Münchner Weißwurst” megnevezésű termékben, amelyben romlás jelei mutatkoztak." - írják a honlapjukon.

Termék neve: Zimmermann Bio Münchner Weißwurst (müncheni fehér kolbász)
Probléma jellege: szulfitredukáló Clostridium baktérium jelenléte
Az érintett termék azonosító adatai:
Megnevezés: Bio Münchner Weißwurst (müncheni fehér kolbász)
Márka: Zimmermann
Kiszerelés: 4/250 g
Tételszám: 20649
Minőségmegőrzési idő: 31.07.2021
















